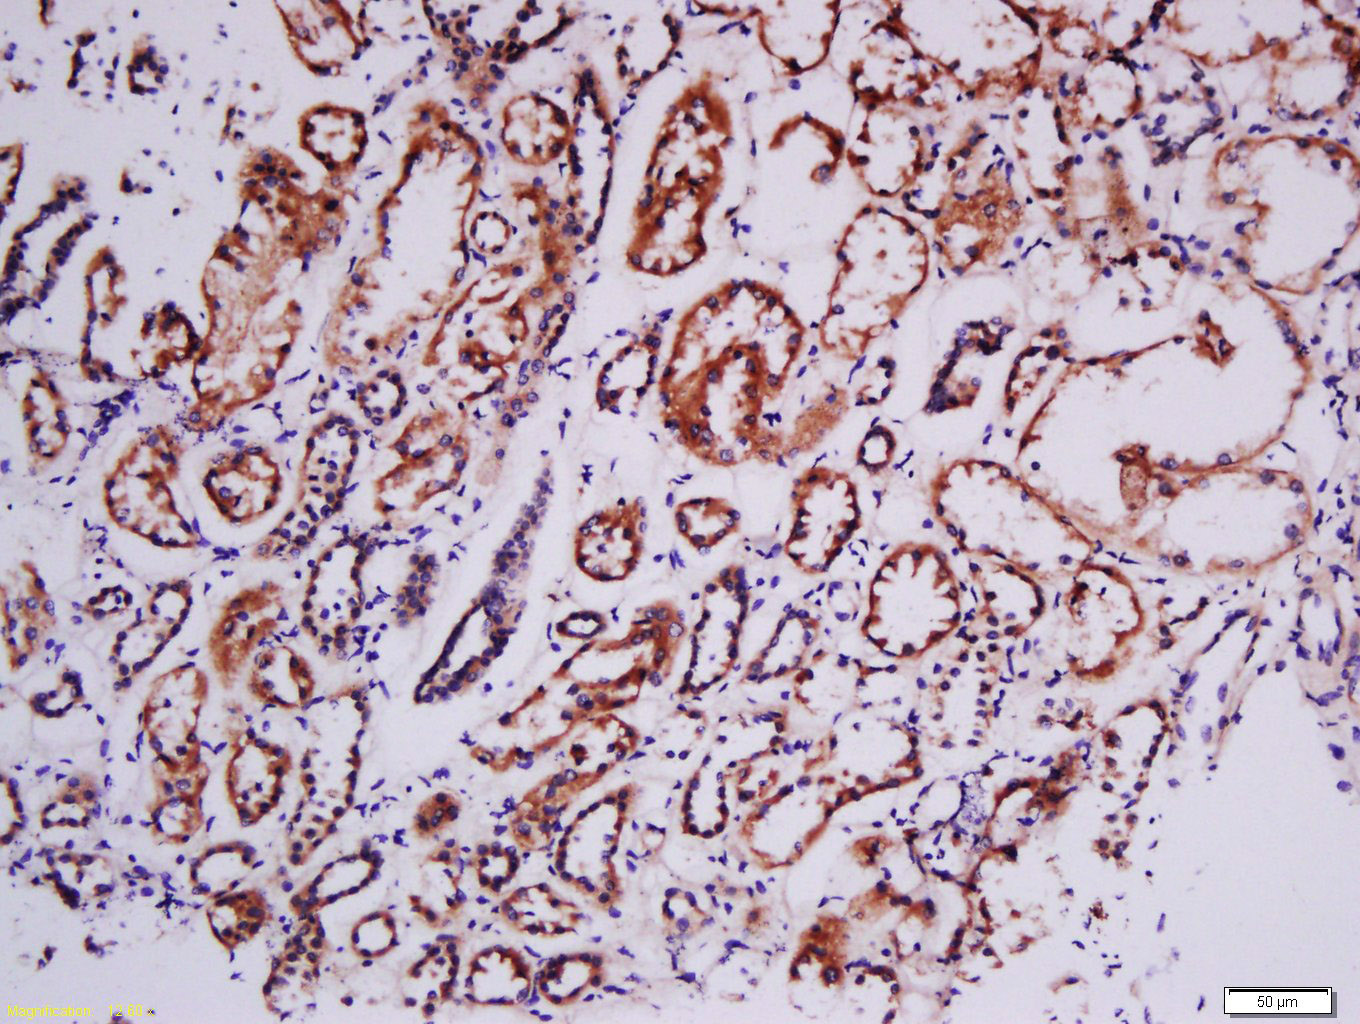
phospho-RSK2 (Tyr529) Rabbit p

Tissue/cell: human kidney tissue; 4% Paraformaldehyde-fixed and paraffin-embedded;
Antigen retrieval: citrate buffer ( 0.01M, pH 6.0 ), Boiling bathing for 15min; Block endogenous peroxidase by 3% Hydrogen peroxide for 30min; Blocking buffer (normal goat serum,C-0005) at 37℃ for 20 min;
Incubation: Anti-Phospho-RSK2(Tyr529) Polyclonal Antibody, Unconjugated(bs-3368R) 1:200, overnight at 4°C, followed by conjugation to the secondary antibody(SP-0023) and DAB(C-0010) staining
相关产品推荐更多 >

phospho-HSD17B13 (Ser33) Rabbit pAb, BF405 conjugated(bs-22308R-BF405)-100ul
¥2980
TYROBP Rabbit pAb, Cy5 conjugated(bs-12630R-Cy5)-100ul
¥2980
MTNR1A Rabbit pAb, Biotin conjugated(bs-0027R-Bio)-100ul
¥2980
LCN10 Rabbit pAb(bs-18192R)-50ul/100ul/200ul
¥1180
Dopamine Transporter Rabbit pAb, AP conjugated(bs-1714R-AP)-100ul
¥2980
万千商家帮你免费找货
0 人在求购买到急需产品
- 详细信息
- 技术资料
- 应用范围:
产品信息以Bioss网站为准
- 规格:
50ul/100ul/200ul
| 规格: | 50ul | 产品价格: | ¥1180.0 |
|---|---|---|---|
| 规格: | 100ul | 产品价格: | ¥1980.0 |
| 规格: | 200ul | 产品价格: | ¥2800.0 |
| 产品编号 | bs-3368R |
| 英文名称 | phospho-RSK2 (Tyr529) Rabbit pAb |
| 中文名称 | 磷酸化核糖体S6激酶RSK2抗体 |
| 英文别名 | RSK2(phospho Tyr529); RSK2(phospho Y529); Rsk 2; MAPKAP Kinase 1b; MAP kinase activated protein kinase 1b; MAPK activated protein kinase 1b; 90 kDa ribosomal protein S6 kinase 3; HU2; HU3; Insulin stimulated protein kinase 1; ISPK1; MAPKAPK 1b; MAPKAPK1B; MRX19; p90 RSK3; p90RSK3; pp90RSK2; Ribosomal protein S6 kinase 90kDa polypeptide 3; Ribosomal protein S6 kinase alpha 3; Ribosomal S6 kinase 2; RPS6KA3; S6 kinase 2; S6K alpha3; KS6A3_HUMAN; CLS; RSK; HU-3; RSK2; MRX19; ISPK-1; p90-RSK2; S6K-alpha3. |
| 产品应用 | IHC-P=1:100-500, IHC-F=1:100-500, IF=1:100-500 Not yet tested in other applications. |
| 交叉反应 | Human (Mouse, Rat, Chicken, Dog, Pig, Cow, Horse, Rabbit) |
| 抗体来源 | Rabbit |
| 免疫原 | KLH conjugated Synthesised phosphopeptide derived from human RSK2 around the phosphorylation site of Tyr529 |
| 亚型 | IgG |
| 性状 | Liquid |
| 纯化方法 | affinity purified by Protein A |
| 克隆类型 | Polyclonal |
| 理论分子量 | 84 kDa |
| 浓度 | 1mg/ml |
| 储存液 | 0.01M TBS (pH7.4) with 1% BSA, 0.02% Proclin300 and 50% Glycerol. |
| 研究领域 | Signal Transduction > Protein Phosphorylation > Ser / Thr Kinases > MAPK Pathway |
| 亚基 | Forms a complex with either MAPK1/ERK2 or MAPK3/ERK1 in quiescent cells. Transiently dissociates following mitogenic stimulation. Interacts with NFATC4, ETV1/ER81 and FGFR1. |
| 亚细胞定位 | Nucleus. Cytoplasm. |
| 组织特异性 | Expressed in many tissues, highest levels in skeletal muscle. |
| 翻译后修饰 | Activated by phosphorylation at Ser-227 by PDPK1. Autophosphorylated on Ser-386, as part of the activation process. May be phosphorylated at Thr-365 and Ser-369 by MAPK1/ERK2 and MAPK3/ERK1. Can also be activated via phosphorylation at Ser-386 by MAPKAPK2. N-terminal myristoylation results in an activated kinase in the absence of added growth factors. |
| 相似性 | Belongs to the protein kinase superfamily. AGC Ser/Thr protein kinase family. S6 kinase subfamily. Contains 1 AGC-kinase C-terminal domain. Contains 2 protein kinase domains. |
| 功能 | Serine/threonine-protein kinase that acts downstream of ERK (MAPK1/ERK2 and MAPK3/ERK1) signaling and mediates mitogenic and stress-induced activation of the transcription factors CREB1, ETV1/ER81 and NR4A1/NUR77, regulates translation through RPS6 and EIF4B phosphorylation, and mediates cellular proliferation, survival, and differentiation by modulating mTOR signaling and repressing pro-apoptotic function of BAD and DAPK1. In fibroblast, is required for EGF-stimulated phosphorylation of CREB1 and histone H3 at 'Ser-10', which results in the subsequent transcriptional activation of several immediate-early genes. In response to mitogenic stimulation (EGF and PMA), phosphorylates and activates NR4A1/NUR77 and ETV1/ER81 transcription factors and the cofactor CREBBP. Upon insulin-derived signal, acts indirectly on the transcription regulation of several genes by phosphorylating GSK3B at 'Ser-9' and inhibiting its activity. Phosphorylates RPS6 in response to serum or EGF via an mTOR-independent mechanism and promotes translation initiation by facilitating assembly of the preinitiation complex. In response to insulin, phosphorylates EIF4B, enhancing EIF4B affinity for the EIF3 complex and stimulating cap-dependent translation. Is involved in the mTOR nutrient-sensing pathway by directly phosphorylating TSC2 at 'Ser-1798', which potently inhibits TSC2 ability to suppress mTOR signaling, and mediates phosphorylation of RPTOR, which regulates mTORC1 activity and may promote rapamycin-sensitive signaling independently of the PI3K/AKT pathway. Mediates cell survival by phosphorylating the pro-apoptotic proteins BAD and DAPK1 and suppressing their pro-apoptotic function. Promotes the survival of hepatic stellate cells by phosphorylating CEBPB in response to the hepatotoxin carbon tetrachloride (CCl4). Is involved in cell cycle regulation by phosphorylating the CDK inhibitor CDKN1B, which promotes CDKN1B association with 14-3-3 proteins and prevents its translocation to the nucleus and inhibition of G1 progression. In LPS-stimulated dendritic cells, is involved in TLR4-induced macropinocytosis, and in myeloma cells, acts as effector of FGFR3-mediated transformation signaling, after direct phosphorylation at Tyr-529 by FGFR3. Phosphorylates DAPK1. |
| 保存条件 | Shipped at 4℃. Store at -20℃ for one year. Avoid repeated freeze/thaw cycles. |
| 注意事项 | This product as supplied is intended for research use only, not for use in human, therapeutic or diagnostic applications. |
| 背景资料 | This gene encodes a member of the RSK (ribosomal S6 kinase) family of serine/threonine kinases. This kinase contains 2 non-identical kinase catalytic domains and phosphorylates various substrates, including members of the mitogen-activated kinase (MAPK) signalling pathway. The activity of this protein has been implicated in controlling cell growth and differentiation. Mutations in this gene have been associated with Coffin-Lowry syndrome (CLS). [provided by RefSeq, Jul 2008] |
| 应用 | 推荐稀释比例 |
| {IHC-P} | {1:100-500} |
| {IHC-F} | {1:100-500} |
| {IF} | {1:100-500} |
风险提示:丁香通仅作为第三方平台,为商家信息发布提供平台空间。用户咨询产品时请注意保护个人信息及财产安全,合理判断,谨慎选购商品,商家和用户对交易行为负责。对于医疗器械类产品,请先查证核实企业经营资质和医疗器械产品注册证情况。
技术资料暂无技术资料 索取技术资料
phospho-RSK2 (Tyr529) Rabbit pAb(bs-3368R)-50ul/100ul/200ul
¥1180 - 2800





